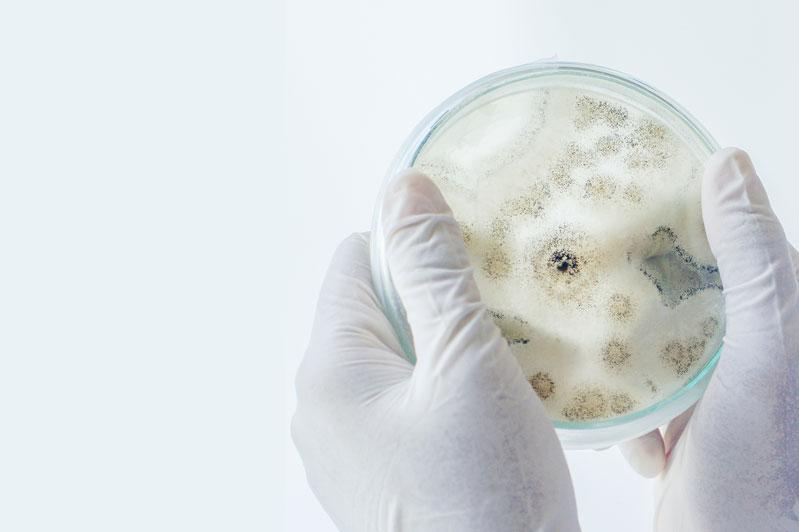
Mould Inspection by Adelaide mould expert - Assessment, sampling and lab report - 25+ years experience

Mould Inspections, Testing and Labs
We have extensive experience conducting moisture assessments and testing of mould using our in-house lab.
Mould inspection with air and surface sampling
We perform site examination to assess mould conditions by investigating moisture intrusion, assessing surface and in air dampness (humidity), along with collecting surface and air samples to test for fungal activity in water damaged buildings.
Site inspection to assess water damaged buildings typically includes:
- Moisture measurements and mapping.
- Lab analysis with risk guidance, and recommendations compliant with Australian and International standards.
- Other indoor air quality testing considerations.
- Insurance assessments to source water damage and extent, and development of remediation scopes for contents and buildings.
- Mould avoidance strategies.
- Further investigation for the presence of actual, potential or hidden mould growth and bacteria (Fecal Coliforms, E. Coli, and Enterococcus).
- Post remediation verification to enable re-occupation of remediated areas.
Assessment report
We use the forensic data and site intelligence to assess mould species and concentrations, drawing comparison against outdoor “normal” background fungal ecology. Our detailed inspection reports help to delineate impacts and define an appropriate scope of work for mould remediation – ultimately to mitigate health and building impacts.
Our reports are suitable for insurance assessment and remediation strategies.
Laboratory testing
We compare our laboratory results against known guidelines and environmental parameters to provide appropriate risk guidance and recommendations, in cooperation with restoration professionals, insurers, and builders to address moisture concerns and building defects.
Post remediation inspection and verification
Post remediation verification is also performed to ensure remediation is performed to an acceptable level for habitation (where necessary).
FAQs
Inspection services
Mould information
Mould inspection photos








Questions?
Contact Andrew on 0476 943 768
